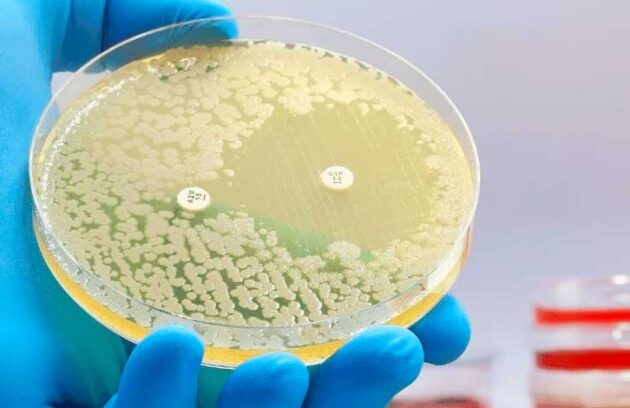

Pesquisadores passaram a treinair uma inteligência artificial (IA) capaz de avaliar expressões faciais para identificar doenças degenerativas
Após pesquisa, entenda por que o consumo exagerado de Xilitol aumenta risco de doença cardíaca em até 2 vezes
Após pesquisa, entenda por que o consumo exagerado de Xilitol aumenta risco de doença cardíaca em até 2 vezes
Confira mais detalhes sobre a pesquisa que identificou quase 1 milhão de substâncias contra bactérias resistentes!
Saiba como células naturais podem ter a capacidade de ampliar o acesso à terapia avançada contra o câncer
Entenda como os transtornos mentais e doenças reumáticas autoimunes podem estar relacionados; confira os resultados do estudo!